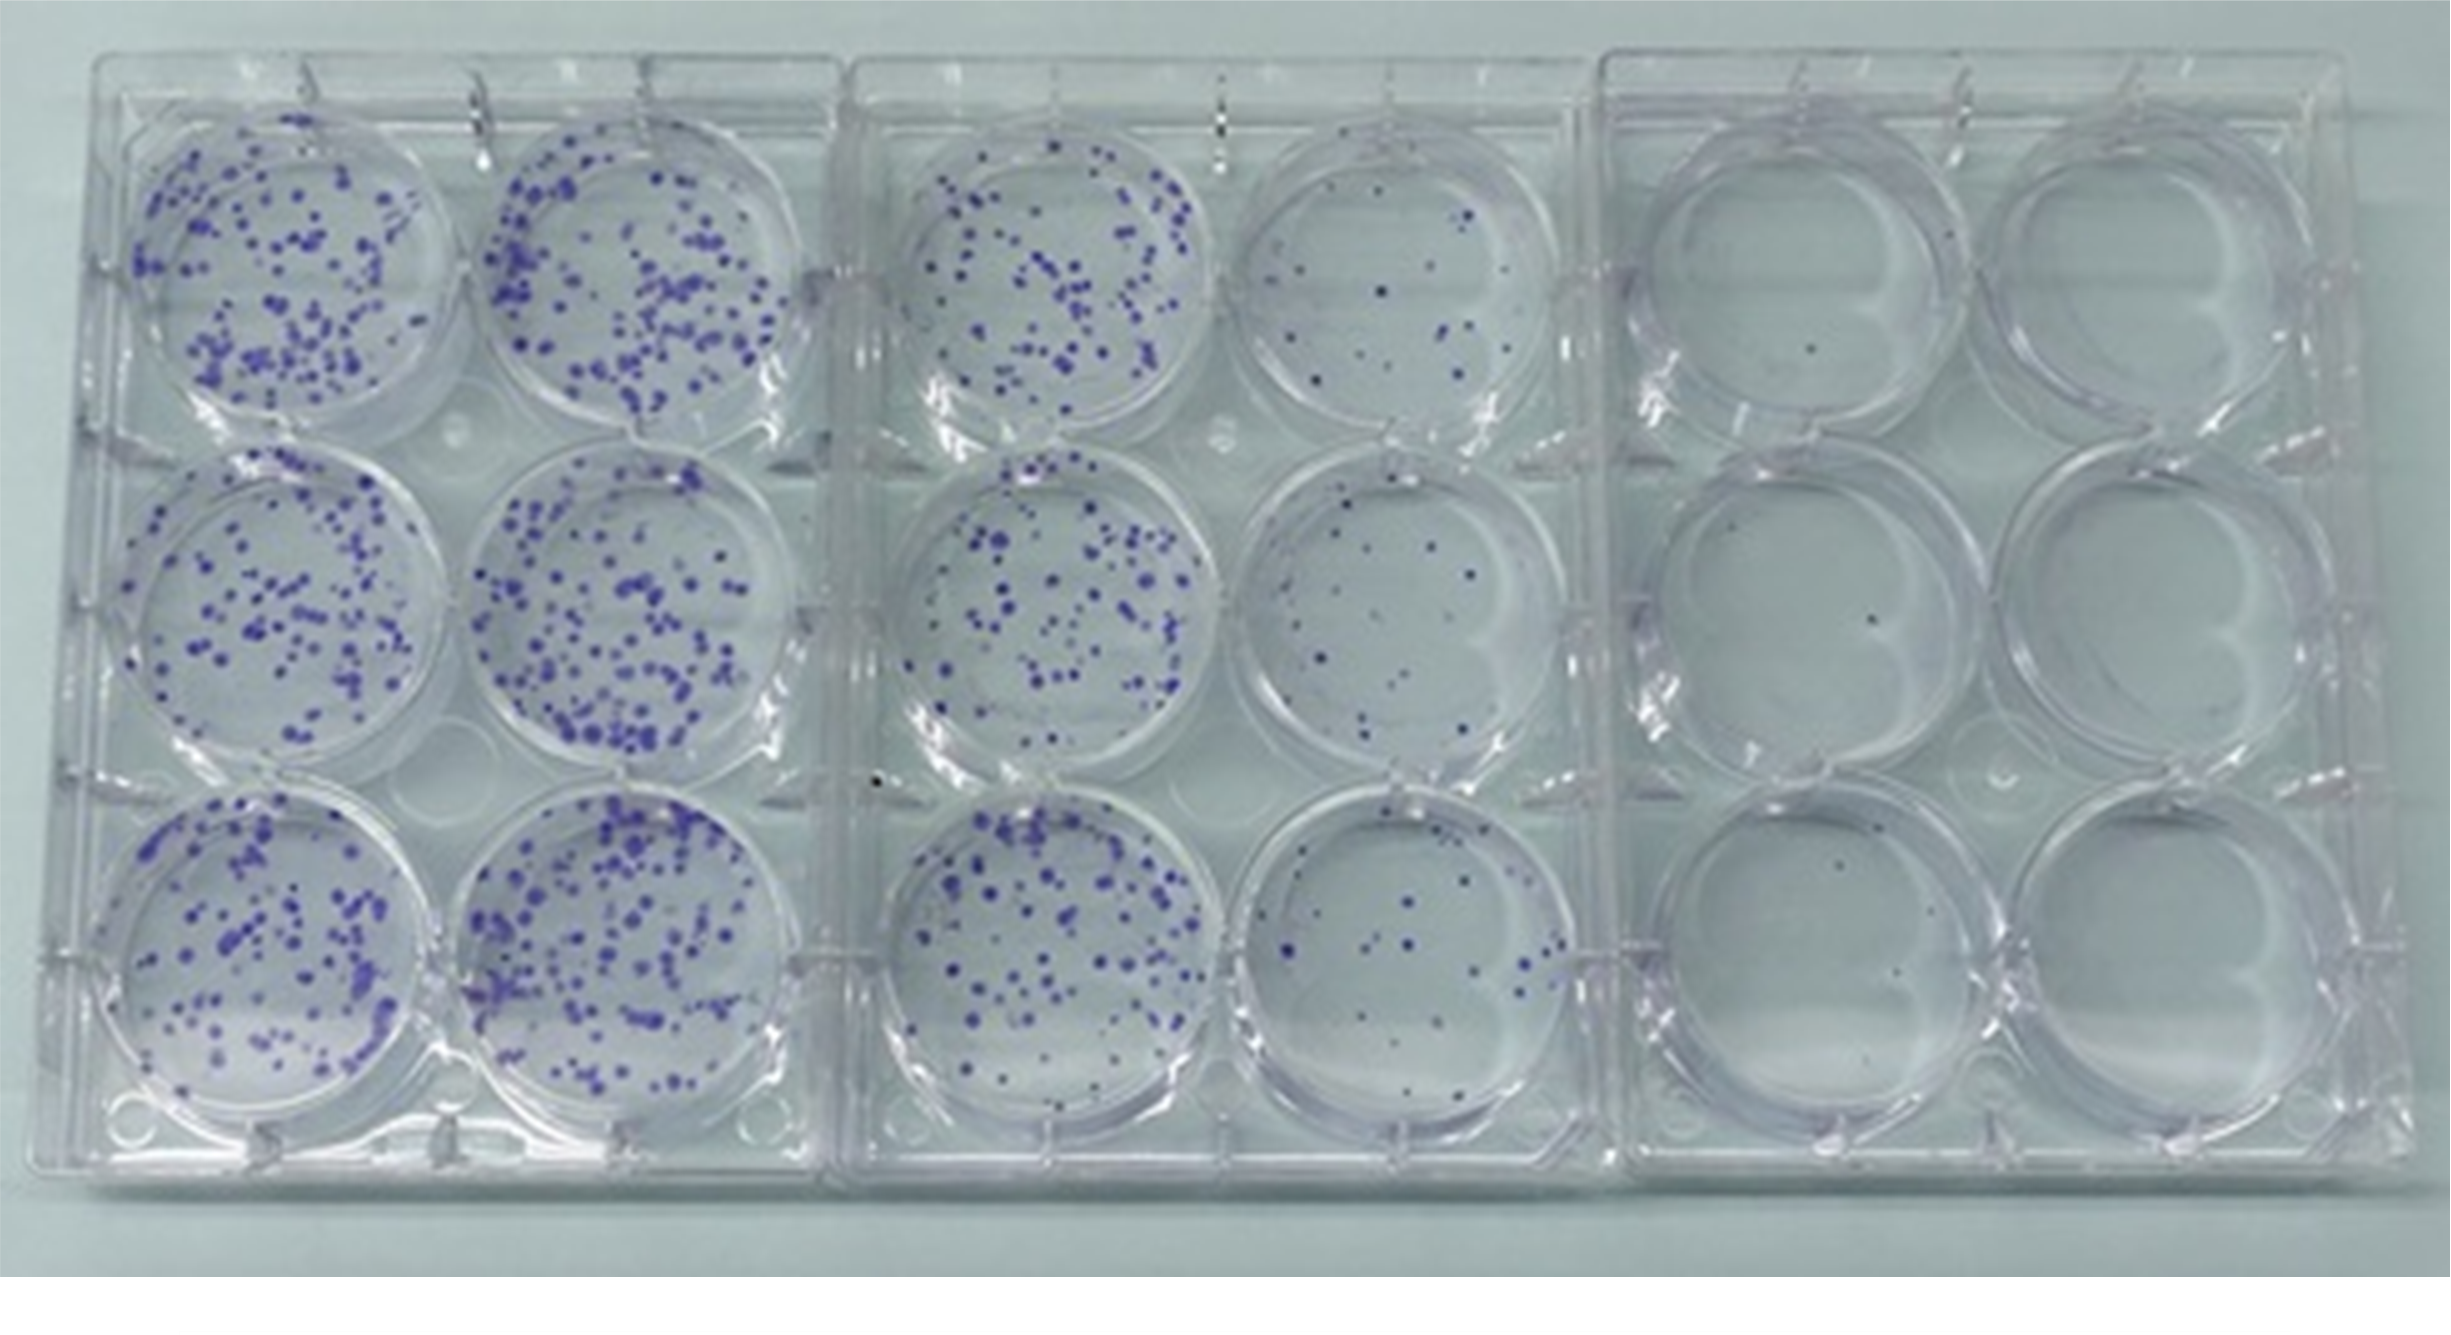

細胞毒性試験
細胞毒性試験は、医療機器、化学物質および化粧品などの安全性を、ほ乳類の培養細胞を用いて細胞の生死を指標として毒性を評価する方法です。
【関連ページ】 安全性試験>細胞毒性試験、 代替法
コロニー形成による細胞毒性試験
DSTCでは主に、抽出液や直接接触によるコロニー形成試験を実施しており、いずれもV79細胞を用い、ISO 10993-5、日本薬局方、医療機器ガイドラインなどに準拠しています。
抽出法
被験物質を培地に浸漬して抽出液を調製し、その抽出液で5~6日間培養後に形成されたコロニー数から毒性を判定します。
抽出法によるコロニー形成試験 (V79細胞)

0.25% ZDBC含有ポリウレタンフィルム抽出液によるコロニー形成試験(ギムザ染色)
左の図は、弱い細胞毒性を有する陽性対照材料、0.25% Zinc dibutyldithiocarbamate (ZDBC) ポリウレタンフィルムの抽出液 (37℃で72時間振とう抽出) で処理した、プレートのギムザ染色写真です。抽出液の濃度が右側に向かって高くなるにつれて、細胞毒性の影響によりコロニー数の減少が確認できます。右図は、左図のコロニー数から算出したコロニー形成率 (%) のグラフです。図中のIC₅₀=52.19%は、コロニー形成率が50%に低下する抽出液の濃度を示しています。
直接接触法
被験物質の上に直接細胞を播種し、コロニー形成の有無を評価する方法です。
細胞の接着が困難な場合はインサートを用いた間接接触法により実施可能です。
定量的な細胞毒性試験
定量的な評価の試験として、ニュートラルレッド (NRU) 試験、WST-8法、遊離LDH法を実施しています。これら試験はマイクロプレートリーダーで測定した吸光度を指標として、細胞の生存率や毒性の程度を評価しています。
特に3T3細胞を用いたNRU試験は、その試験結果から単回投与毒性のLD50値の予測(OECDガイダンス [GD129])、LD50値が2000 mg/kgを超えるか否かの評価 (医薬部外品ガイダンス) に活用されています。
NRU (ニュートラルレッド取り込み) 試験 (Balb/3T3細胞)

NRを取り込んだ試験後のプレート写真
定性的な細胞毒性試験
定性的な評価の試験として、USP <87>およびISO 10993-5に準拠したElution Test (溶出試験) を実施しており、医療機器や生体材料から溶出する化学物質が、細胞に与える毒性の有無をグレード分けし評価をしています。
Elution Test (L929細胞)
 USP <87>に基づくElution Testの顕微鏡観察像
USP <87>に基づくElution Testの顕微鏡観察像【関連ページ】 安全性試験>細胞毒性試験、 代替法